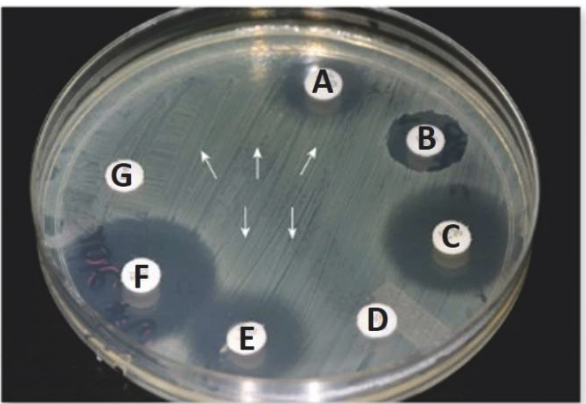

1/35
Looks like no tags are added yet.
Name  | Mastery  | Learn  | Test  | Matching  | Spaced  | 
|---|
No study sessions yet.
Which are characteristics of an ideal antimicrobial drug?
(a) Microbiostatic rather than microbicidal
(b) Slow or nonexistent development of antimicrobial resistance
(c) Toxic to microbe but nontoxic to the host
(d) Prevents host’s immune response from interfering with its effects
(e) Soluble in body fluids
(f) Quickly inactivated to reduce toxic effects to the host
(a) Microbiostatic rather than microbicidal ❌
Ideally, drugs should be microbicidal (kill the pathogen) rather than just inhibit growth.
Microbiostatic drugs are sometimes used, but they are not the ideal choice.
(b) Slow or nonexistent development of antimicrobial resistance ✅
An ideal drug should not easily promote microbial resistance, so it remains effective long-term.
(c) Toxic to microbe but nontoxic to the host ✅
This is the principle of selective toxicity — one of the most important characteristics.
(d) Prevents host’s immune response from interfering with its effects ❌
Ideally, the drug should work with the immune system, not prevent it from acting.
(e) Soluble in body fluids ✅
To reach the site of infection, a drug must be soluble and stable in body fluids.
(f) Quickly inactivated to reduce toxic effects to the host ❌
The drug should remain active long enough to destroy the microbe, not be inactivated quickly.
Briefly describe the characteristics of an ideal antimicrobial drug.
An ideal antimicrobial drug is:
Selectively toxic (kills microbes, not the host)
Resistant to inactivation and
Soluble in body fluids (in order to reach the site of infection)
Stable and effective over time
Unlikely to cause resistance
The term antimicrobials describes ________________.
The term antimicrobials describes any drug that works against microbes, no matter which microbes are targets.
The use of a drug to prevent imminent infection of a person at risk is called ________________.
The use of a drug to prevent imminent infection of a person at risk is called prophylaxis.
The use of chemotherapeutic drugs to control infection and diseases caused by many types of microorganisms is called __________ chemotherapy.
The use of chemotherapeutic drugs to control infection and diseases caused by many types of microorganisms is called antimicrobial chemotherapy.
T or F: An antibiotic is a substance produced by the natural metabolic processes of some microorganisms.
True
Why do some microbes produce antibiotics?
Some microbes produce antibiotics naturally to inhibit or kill other competing microbes in their environment.
T or F: Antimicrobial drugs are difficult to make because substances that are toxic to the bacteria are likely to be toxic to the host.
True
Provide 2 reasons why it’s difficult to make effective antimicrobial drugs for human pathogens.
Drugs that are toxic to bacteria that infects humans is also likely to be toxic to the host
Penicillin is _________.
(a) Chemically synthesized in a laboratory
(b) Naturally-derived from the Penicillium fungus
(c) Harvested from genetically-modified bacteria
(d) Naturally-derived from Streptomyces bacteria
The answer is (b)
Penicillin is naturally-derived from the penicillium fungus
An all-inclusive term for any drug used to fight an infection, regardless of what type of microbe it targets, is ____________.
An all-inclusive term for any drug used to fight an infection, regardless of what type of microbe it targets, is antimicrobial.
Prophylaxis is a practice of administering an antimicrobial drug ______.
(a) when symptoms of an infectious illness first appear
(b) before onset of infection
(c) throughout full course of the infection, from start of symptoms until they’re no longer present
(b) before onset of infection
Prophylaxis means preventive treatment — using an antimicrobial drug before an infection occurs to prevent disease.
It’s commonly used:
Before surgery to prevent postoperative infections.
Before dental procedures in patients at risk of endocarditis.
In people exposed to certain pathogens (e.g., malaria prophylaxis).
Antimicrobial chemotherapy is a _________ term used to describe the use of drugs to control infections caused by _________.
Antimicrobial chemotherapy is a general term used to describe the use of drugs to control infections caused by (a variety of) microbes.
The _________ technique is an agar diffusion test to determine antibiotic susceptibility of a particular bacterial strain.
(a) Southern blot
(b) Kirby-Bauer
(c) Sanger method
(d) Therapeutic index
(b) Kirby-Bauer technique is an agar diffusion test to determine antibiotic susceptibility.
A substance produced by the natural metabolic processes of some microorganisms, and that can inhibit or kill other microorganisms, usually targeting bacteria, is a(n) ____________.
A substance produced by the natural metabolic processes of some microorganisms, and that can inhibit or kill other microorganisms, usually targeting bacteria, is a(n) antibiotic.
Consider the relative sizes of the zones of inhibition surrounding the antibiotic discs in the image. Provide a brief analysis of the effect of each antibiotic (A-G) on the microbe in the petri dish.
Microbe is likely susceptible to antibiotics C & F
Microbe is resistant to antibiotics D & G
Microbe is somewhat inhibited by antibiotics B & E
Penicillin is a narrow-spectrum antibiotic that is naturally produced by a(n) ________ named Penicillium.
Penicillin is a narrow-spectrum antibiotic that is naturally produced by a(n) fungi named Penicillium.
The ratio of toxic dose to the effect dose of a drug use to assess its safety and reliability, is called the _____________________.
The ratio of toxic dose to the effect dose of a drug use to assess its safety and reliability, is called the therapeutic index .
The property of an antimicrobial agent to be highly toxic against its target microbe while being far less toxic to the cells of the host organism is called _________ toxicity.
The property of an antimicrobial agent to be highly toxic against its target microbe while being far less toxic to the cells of the host organism is called selective toxicity.